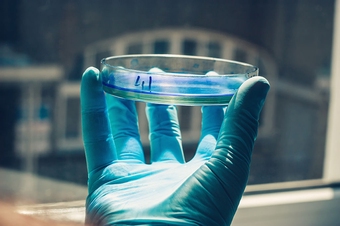
petri dish

A petri dish is a shallow, round dish with a lid that is used to grow microorganisms in a controlled environment. It is made of glass or plastic and has a flat bottom and a slightly curved lid. The lid helps to keep the microorganisms inside the dish from drying out and from being contaminated by other microorganisms in the air.
Petri dishes are widely used in biology to cultivate microorganisms such as bacteria, yeasts, and moulds. They are also used in other fields, such as chemistry and genetics.
Petri dishes are prepared with a growth medium, which is a nutrient-rich agar solution. The agar solidifies when it cools, creating a solid surface on which the microorganisms can grow.
Microorganisms are added to the petri dish using a sterile loop or pipette. The microorganisms are then allowed to grow for a period of time, typically several days. During this time, the microorganisms will reproduce and form colonies.
The colonies can be observed under a microscope to identify the type of microorganism and to study its growth. Petri dishes can also be used to test the effectiveness of antibiotics or other treatments against microorganisms.
Petri dishes are a versatile and essential tool for scientists who study microorganisms. They are a reliable and affordable way to grow and study microorganisms in a controlled environment.
The Petri dish was filled with a nutrient agar that supported the growth of bacteria.